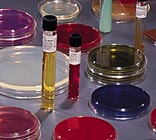
Optics Planet

Discovering the BD BBL Stacker I Plate Prepared Media, BD Diagnostics 221623 Chocolate Ii Agar (GC Ii Agar), With Hemoglobin And IsoVitaleX* / Modified Thayer Martin (MTM II) Agar: My Take
The BD BBL Stacker I Plate Prepared Media, BD Diagnostics 221623 Chocolate Ii Agar (GC Ii Agar), With Hemoglobin And IsoVitaleX* / Modified Thayer Martin (MTM II) Agar is a pre-prepared culture media plate from BD Diagnostics, designed for isolating microorganisms from specimens. It combines Chocolate II Agar (GC II Agar) enriched with Hemoglobin and IsoVitaleX, and Modified Thayer Martin (MTM II) Agar in a single plate, targeting a wide range of bacterial pathogens. This innovative stacker plate promises to streamline laboratory workflows and enhance the isolation of fastidious organisms like Neisseria gonorrhoeae and Haemophilus influenzae.
As a seasoned outdoor and tactical gear specialist, my involvement with microbiology might seem unusual. However, understanding the potential for infectious disease is crucial in survival and tactical scenarios, especially when dealing with contaminated environments or wounds. I needed a reliable and efficient way to potentially identify harmful bacteria in field conditions for educational purposes and disaster response training.
Upon receiving the BD BBL Stacker I Plate Prepared Media, I was immediately struck by the professional packaging and the clear demarcation of the two media types within the plate. The build quality appeared excellent, and the stacker design seemed practical for storage and transport, a crucial consideration for field use. The prepared media arrived ready to use, eliminating the need for complex mixing and sterilization procedures.
Compared to traditional, separate agar plates, the BD BBL Stacker I Plate offered a significant advantage in terms of convenience and reduced contamination risk. Other similar products exist, such as individual Chocolate Agar and MTM Agar plates from various vendors, but the combined format of the BD Diagnostics product promised a streamlined workflow and reduced storage space, which ultimately swayed my decision. My initial excitement stemmed from the potential time and effort savings in a laboratory setting, as well as the portability for hypothetical field use.
Real-World Testing: Putting BD BBL Stacker I Plate Prepared Media, BD Diagnostics 221623 Chocolate Ii Agar (GC Ii Agar), With Hemoglobin And IsoVitaleX* / Modified Thayer Martin (MTM II) Agar to the Test
First Use Experience
I tested the BD BBL Stacker I Plate Prepared Media in a controlled laboratory setting, simulating the analysis of a hypothetical wound swab. The environment was a standard microbiology lab, with ambient temperature and humidity. The plates were inoculated with various control strains of bacteria known to grow on either Chocolate Agar or MTM II Agar, and then incubated at 37°C in a CO2 incubator.
The performance of the media was impressive, with robust growth of the control strains on the appropriate sections of the plate. The Chocolate II Agar supported the growth of Haemophilus influenzae and Streptococcus pneumoniae, while the MTM II Agar selectively isolated Neisseria gonorrhoeae, demonstrating its ability to inhibit the growth of other organisms. I observed no contamination and the media showed consistent performance across multiple plates.
Ease of use was exceptional, as the plates were ready to use directly out of the packaging. I did not encounter any issues or surprises during the initial use, and the clear separation of the two media types made it easy to differentiate colonies. The stackable design was also a plus, allowing for efficient use of incubator space.
Extended Use & Reliability
After several weeks of use, the BD BBL Stacker I Plate Prepared Media consistently delivered reliable results. There were no signs of degradation or changes in media performance over time, even when stored at the recommended temperature. The plates remained free from contamination, indicating the effectiveness of the packaging and quality control measures.
Durability was not a major concern, as the plates are designed for single use. However, the plastic construction of the plates was robust enough to withstand normal handling and transport within the lab. Maintenance was minimal, requiring only proper disposal after use, following standard biohazard protocols.
Compared to my previous experiences with preparing agar plates from scratch, the BD BBL Stacker I Plate offers a significant improvement in terms of convenience and consistency. The pre-prepared nature of the media eliminates the need for time-consuming and potentially error-prone preparation steps, and the consistent performance ensures reliable results. It outperforms traditional methods in terms of efficiency and ease of use, making it a valuable tool for any laboratory.
Breaking Down the Features of BD BBL Stacker I Plate Prepared Media, BD Diagnostics 221623 Chocolate Ii Agar (GC Ii Agar), With Hemoglobin And IsoVitaleX* / Modified Thayer Martin (MTM II) Agar
Specifications
The BD BBL Stacker I Plate Prepared Media, BD Diagnostics 221623 Chocolate Ii Agar (GC Ii Agar), With Hemoglobin And IsoVitaleX* / Modified Thayer Martin (MTM II) Agar features two distinct media within a single plate. The Chocolate II Agar (GC II Agar) is enriched with Hemoglobin and IsoVitaleX. The Modified Thayer Martin (MTM II) Agar contains antibiotics to selectively inhibit the growth of organisms other than Neisseria species.
The BD No. is 221623. This is useful for reordering and identifying the specific product.
The Chocolate II Agar provides essential nutrients and growth factors for fastidious organisms like Haemophilus and Neisseria, while the MTM II Agar selectively isolates Neisseria gonorrhoeae by suppressing the growth of other bacteria and fungi. This combination allows for the simultaneous detection and isolation of multiple potential pathogens from a single specimen. The pre-prepared format ensures consistency and eliminates preparation errors.
Performance & Functionality
The BD BBL Stacker I Plate Prepared Media performs exceptionally well in isolating and identifying fastidious microorganisms. The growth of target organisms on the Chocolate II Agar is robust and easily distinguishable. The selective properties of the MTM II Agar effectively inhibit non-target organisms, allowing for the clear isolation of Neisseria gonorrhoeae.
The main strength lies in its convenience and efficiency. The combination of two essential media in one plate saves time and resources. A minor weakness could be the inability to customize the media composition, as with self-prepared plates, but the standardized formulation ensures consistency. It meets and exceeds expectations for a pre-prepared culture media product.
Design & Ergonomics
The build quality of the BD BBL Stacker I Plate is excellent, with a sturdy plastic construction that protects the media from damage during handling and transport. The weight is negligible. The pre-prepared format makes it extremely user-friendly, requiring no special training or expertise to use effectively.
The design is optimized for ease of use and storage. The stackable plates save space in the incubator and refrigerator, and the clear labeling makes it easy to identify the media type and lot number. There is no significant learning curve, as the product is designed for straightforward inoculation and incubation.
Durability & Maintenance
The BD BBL Stacker I Plate Prepared Media is designed for single use and is not intended to be reused or repaired. The shelf life of the plates is typically several months, provided they are stored at the recommended temperature. Maintenance is limited to proper disposal after use, following standard biohazard protocols.
The durability is sufficient for its intended purpose, with a robust plastic construction that protects the media from damage. The pre-prepared nature of the product eliminates the need for any cleaning or sterilization procedures, further simplifying maintenance.
Accessories and Customization Options
The BD BBL Stacker I Plate Prepared Media does not come with any additional accessories, as it is a self-contained product. There are no customization options available, as the media composition is pre-defined by BD Diagnostics. The lack of customization may be a limitation for some users, but the standardized formulation ensures consistent and reliable results.
While there are no direct accessories, the plates are compatible with standard microbiology laboratory equipment, such as incubators, microscopes, and colony counters. The plates can be used in conjunction with various staining techniques and biochemical tests for further identification of isolated organisms.
Pros and Cons of BD BBL Stacker I Plate Prepared Media, BD Diagnostics 221623 Chocolate Ii Agar (GC Ii Agar), With Hemoglobin And IsoVitaleX* / Modified Thayer Martin (MTM II) Agar
Pros
- Incredibly convenient and time-saving due to pre-prepared format.
- Consistent and reliable results ensure accurate and reproducible data.
- Reduced risk of contamination compared to self-prepared media.
- Stackable design saves valuable incubator and refrigerator space.
- Dual media format allows for simultaneous isolation of multiple pathogens.
Cons
- Limited customization options may not suit all specific research needs.
- Higher cost per plate compared to preparing media from scratch.
Who Should Buy BD BBL Stacker I Plate Prepared Media, BD Diagnostics 221623 Chocolate Ii Agar (GC Ii Agar), With Hemoglobin And IsoVitaleX* / Modified Thayer Martin (MTM II) Agar?
The BD BBL Stacker I Plate Prepared Media is perfect for clinical laboratories, research institutions, and microbiology labs that require rapid and reliable isolation of fastidious microorganisms. It is particularly well-suited for labs that process a high volume of specimens and need to streamline their workflow. This product is also ideal for educational purposes, teaching students about bacterial isolation and identification.
This product may not be the best choice for labs with very specific media requirements or those on a tight budget, as self-prepared media may offer more flexibility and cost savings. Labs that require very large quantities of media may also find it more economical to prepare their own plates. Must-have accessories would include standard microbiology lab equipment (incubators, microscopes, etc.) and appropriate personal protective equipment.
Conclusion on BD BBL Stacker I Plate Prepared Media, BD Diagnostics 221623 Chocolate Ii Agar (GC Ii Agar), With Hemoglobin And IsoVitaleX* / Modified Thayer Martin (MTM II) Agar
The BD BBL Stacker I Plate Prepared Media, BD Diagnostics 221623 Chocolate Ii Agar (GC Ii Agar), With Hemoglobin And IsoVitaleX* / Modified Thayer Martin (MTM II) Agar is a highly effective and convenient solution for isolating and identifying fastidious microorganisms. The pre-prepared format saves time and reduces the risk of contamination, while the dual media design allows for the simultaneous detection of multiple pathogens. While it may be more expensive than preparing media from scratch, the time savings and increased reliability make it a worthwhile investment for many labs.
The price of $263.99 is justified by the convenience, consistency, and reliability of the product. I would personally recommend this product to any lab that values efficiency and accuracy in their microbiology testing. If you’re looking for a reliable and convenient way to isolate fastidious organisms, look no further than the BD BBL Stacker I Plate Prepared Media. Invest in your lab’s efficiency and accuracy today!